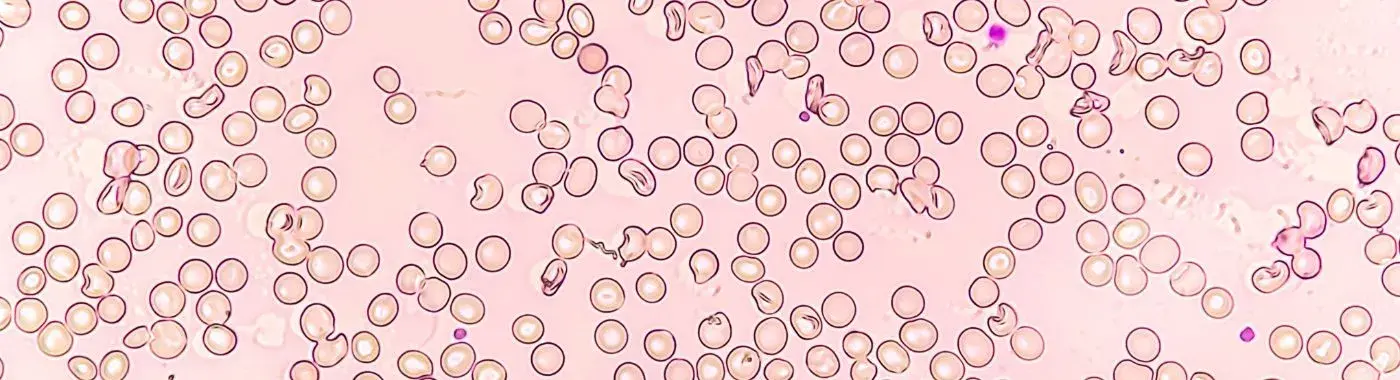
Aplastic Crisis - Causes, Symptoms, Diagnosis, Treatment, and Prevention

- Diseases and Conditions
- Aplastic Crisis - Causes, Symptoms, Diagnosis, Treatment, and Prevention
Aplastic Crisis - Causes, Symptoms, Diagnosis, Treatment, and Prevention
A Comprehensive Guide to Aplastic Crisis
Introduction
Aplastic crisis is a serious medical condition characterized by a sudden and severe decrease in the production of red blood cells, leading to anemia. This condition is particularly significant because it can occur in individuals with underlying health issues, such as sickle cell disease or thalassemia, and can lead to life-threatening complications if not promptly addressed. Understanding aplastic crisis is crucial for early recognition and effective management, which can significantly improve patient outcomes.
Definition
What is Aplastic Crisis?
Aplastic crisis refers to a rapid decline in the bone marrow's ability to produce blood cells, particularly red blood cells. This condition is often triggered by an underlying disease, such as sickle cell disease, where the body is already compromised in its ability to produce healthy blood cells. The crisis can lead to severe anemia, fatigue, and other complications, necessitating immediate medical intervention.
Causes and Risk Factors
Infectious/Environmental Causes
Aplastic crisis can be precipitated by various infectious agents, particularly parvovirus B19, which specifically targets red blood cell precursors in the bone marrow. This virus can cause a significant drop in red blood cell production, especially in individuals with pre-existing hemolytic anemia. Environmental factors, such as exposure to certain chemicals or radiation, can also contribute to the development of aplastic crisis by damaging the bone marrow.
Genetic/Autoimmune Causes
Genetic predispositions play a role in some cases of aplastic crisis. Conditions like Fanconi anemia, a hereditary disorder, can lead to bone marrow failure and increase the risk of an aplastic crisis. Autoimmune disorders, where the body's immune system mistakenly attacks its own cells, can also lead to aplastic anemia and subsequent crises.
Lifestyle and Dietary Factors
While lifestyle factors are less directly linked to aplastic crisis, overall health and nutrition can influence the body's ability to cope with stressors. A diet lacking in essential nutrients, such as vitamins B12 and folate, can impair blood cell production. Additionally, lifestyle choices such as smoking and excessive alcohol consumption can negatively impact bone marrow function.
Key Risk Factors
Several risk factors can increase the likelihood of experiencing an aplastic crisis:
- Age: Aplastic crisis can occur at any age but is more common in children and young adults.
- Gender: There is a slight male predominance in cases of aplastic anemia.
- Geographic Location: Certain regions may have higher incidences of specific infectious agents, such as parvovirus B19.
- Underlying Conditions: Individuals with pre-existing blood disorders, autoimmune diseases, or genetic syndromes are at higher risk.
Symptoms
Common Symptoms of Aplastic Crisis
The symptoms of aplastic crisis can vary but often include:
- Fatigue: A significant drop in red blood cells can lead to extreme tiredness and weakness.
- Pallor: A noticeable paleness of the skin due to reduced hemoglobin levels.
- Shortness of Breath: Difficulty breathing, especially during physical activity, can occur as the body struggles to deliver oxygen.
- Rapid Heart Rate: The heart may beat faster to compensate for low oxygen levels.
- Dizziness or Lightheadedness: Insufficient blood flow can lead to feelings of faintness.
Warning Signs for Immediate Medical Attention
Certain symptoms warrant immediate medical attention, including:
- Severe shortness of breath
- Chest pain
- Confusion or altered mental status
- Uncontrolled bleeding or bruising
- High fever
Diagnosis
Clinical Evaluation
The diagnosis of aplastic crisis begins with a thorough clinical evaluation, including a detailed patient history and physical examination. Healthcare providers will assess symptoms, medical history, and any underlying conditions that may contribute to the crisis.
Diagnostic Tests
Several diagnostic tests are essential for confirming aplastic crisis:
- Complete Blood Count (CBC): This test measures the levels of red blood cells, white blood cells, and platelets, helping to identify anemia and other blood cell deficiencies.
- Bone Marrow Biopsy: A sample of bone marrow is taken to evaluate its cellularity and determine the cause of the blood cell deficiency.
- Reticulocyte Count: This test measures the number of young red blood cells in the blood, indicating the bone marrow's response to anemia.
- Serological Tests: Tests for infectious agents, such as parvovirus B19, may be conducted to identify potential triggers.
Differential Diagnosis
It is crucial to differentiate aplastic crisis from other conditions that can cause similar symptoms, such as:
- Hemolytic anemia
- Leukemia
- Myelodysplastic syndromes
- Nutritional deficiencies (e.g., vitamin B12 or folate deficiency)
Treatment Options
Medical Treatments
The management of aplastic crisis often involves several medical treatments:
- Blood Transfusions: To quickly increase red blood cell levels and alleviate symptoms of anemia.
- Erythropoietin Stimulating Agents: Medications that stimulate the bone marrow to produce more red blood cells.
- Immunosuppressive Therapy: In cases where an autoimmune process is suspected, medications that suppress the immune system may be used.
- Bone Marrow Transplant: In severe cases, a bone marrow transplant may be necessary to restore normal blood cell production.
Non-Pharmacological Treatments
In addition to medical treatments, non-pharmacological approaches can support recovery:
- Dietary Modifications: A balanced diet rich in iron, vitamin B12, and folate can help support blood cell production.
- Lifestyle Changes: Avoiding smoking and limiting alcohol intake can improve overall health and support bone marrow function.
- Alternative Therapies: Some patients may benefit from complementary therapies, such as acupuncture or meditation, to manage stress and improve well-being.
Special Considerations
Different populations may require tailored approaches:
- Pediatric Patients: Treatment may differ based on age and developmental considerations.
- Geriatric Patients: Older adults may have additional comorbidities that complicate treatment and require careful management.
Complications
Potential Complications
If left untreated or poorly managed, aplastic crisis can lead to several complications:
- Severe Anemia: Can result in heart failure or other cardiovascular issues.
- Infections: A low white blood cell count increases the risk of infections, which can be life-threatening.
- Bleeding Disorders: Low platelet counts can lead to easy bruising and uncontrolled bleeding.
Short-Term and Long-Term Complications
Short-term complications may include acute symptoms of anemia and infections, while long-term complications can involve chronic anemia, ongoing blood transfusions, and the potential for developing secondary conditions, such as leukemia.
Prevention
Strategies for Prevention
While not all cases of aplastic crisis can be prevented, certain strategies can reduce the risk:
- Vaccinations: Staying up-to-date with vaccinations can help prevent infections that may trigger a crisis.
- Hygiene Practices: Good hygiene can reduce the risk of infections, especially in immunocompromised individuals.
- Dietary Modifications: A diet rich in essential nutrients can support overall health and blood cell production.
- Lifestyle Changes: Avoiding harmful substances and managing stress can improve overall well-being.
Prognosis & Long-Term Outlook
Typical Course of the Disease
The prognosis for individuals experiencing an aplastic crisis varies based on several factors, including the underlying cause, the severity of the crisis, and the timeliness of treatment. Early diagnosis and intervention are critical for improving outcomes.
Factors Influencing Prognosis
Key factors that influence the overall prognosis include:
- Early Diagnosis: Prompt recognition and treatment can significantly improve recovery prospects.
- Treatment Adherence: Following medical advice and treatment plans is essential for managing the condition effectively.
- Underlying Health: The presence of other health conditions can complicate recovery and affect long-term outcomes.
Frequently Asked Questions (FAQs)
- What are the main symptoms of aplastic crisis?
The main symptoms include fatigue, pallor, shortness of breath, rapid heart rate, and dizziness. If you experience severe symptoms, such as chest pain or confusion, seek immediate medical attention.
- How is aplastic crisis diagnosed?
Diagnosis involves a clinical evaluation, complete blood count, bone marrow biopsy, and tests for infectious agents. These help determine the cause and severity of the condition.
- What treatments are available for aplastic crisis?
Treatment options include blood transfusions, erythropoietin stimulating agents, immunosuppressive therapy, and, in severe cases, bone marrow transplant.
- Can aplastic crisis be prevented?
While not all cases can be prevented, strategies such as vaccinations, good hygiene, and a balanced diet can help reduce the risk.
- What complications can arise from aplastic crisis?
Complications may include severe anemia, infections, and bleeding disorders. Long-term complications can involve chronic anemia and the risk of developing leukemia.
- Is aplastic crisis more common in certain age groups?
Yes, aplastic crisis is more common in children and young adults, although it can occur at any age.
- How long does recovery from aplastic crisis take?
Recovery time varies based on the severity of the crisis and the effectiveness of treatment. Some individuals may recover quickly, while others may require ongoing management.
- Are there lifestyle changes that can help manage aplastic crisis?
Yes, lifestyle changes such as a healthy diet, avoiding smoking, and managing stress can support overall health and improve blood cell production.
- When should I seek medical help for aplastic crisis?
Seek immediate medical attention if you experience severe symptoms like shortness of breath, chest pain, or uncontrolled bleeding.
- Can aplastic crisis lead to other health issues?
Yes, if left untreated, aplastic crisis can lead to complications such as chronic anemia, infections, and an increased risk of leukemia.
When to See a Doctor
It is crucial to seek immediate medical attention if you experience any of the following serious symptoms:
- Severe shortness of breath
- Chest pain or pressure
- Confusion or altered mental status
- Uncontrolled bleeding or bruising
- High fever or signs of infection
Conclusion & Disclaimer
Aplastic crisis is a serious condition that requires prompt recognition and treatment. Understanding its causes, symptoms, and management options can empower individuals to seek timely medical care and improve their outcomes. If you or someone you know is experiencing symptoms of aplastic crisis, do not hesitate to consult a healthcare professional.
Disclaimer: This article is for informational purposes only and does not replace professional medical advice. Always consult a healthcare provider for medical concerns or questions regarding your health.


 Best Hospital Near me Chennai
Best Hospital Near me Chennai

